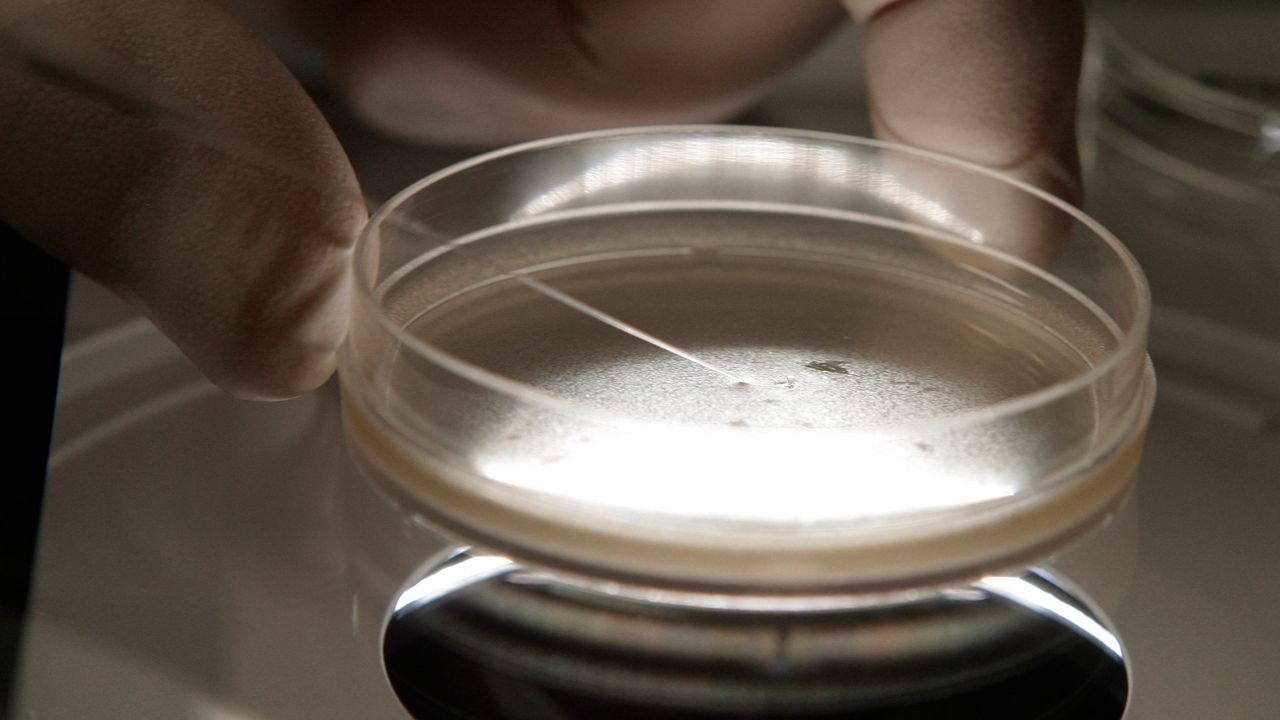

LOUISVILLE, Ky. — A woman is accusing a Kentucky doctor in a lawsuit of using his own sperm during her fertility treatment decades ago without her knowledge.
What You Need To Know
- A woman is suing a doctor for allegedly using his own sperm during her fertility treatment decades ago without her knowledge
- Susan Crowder is filing the suit under a new Kentucky law that sets criminal and civil penalties for fertility fraud
- Dr. Marvin Yussman, now retired, “represented the sperm to be from an anonymous medical student attending the University of Louisville, but in fact, the sperm was from Dr. Yussman himself"
- Crowder’s daughter, who was born in 1976, took a genetic test three years ago
The woman, Susan Crowder, is filing the suit under a new Kentucky law that sets criminal and civil penalties for fertility fraud. Crowder’s attorney, Amy Wheatley, said this is the first such suit under the law, which Crowder lobbied for.
The lawsuit was filed against Dr. Marvin Yussman and the University of Louisville, his former employer.
Yussman, now retired, “represented the sperm to be from an anonymous medical student attending the University of Louisville, but in fact, the sperm was from Dr. Yussman himself,” the lawsuit alleged. The suit was filed Thursday in Jefferson County Circuit Court.
Crowder’s daughter, who was born in 1976, took a genetic test three years ago. Crowder filed a complaint with the state board that issues medical licenses, but “was told that there was insufficient evidence” that Yussman violated state law, the suit said.
A university spokesman said in an email statement that “we hold our health care professionals to the highest standards. While not illegal at the time, the doctor’s actions are not a practice we would condone then or now.”
Crowder, who lives in Longmont, Colorado, advocated for the passage of Kentucky’s Fraudulent Assisted Reproduction Law, which was signed by the governor earlier this year.